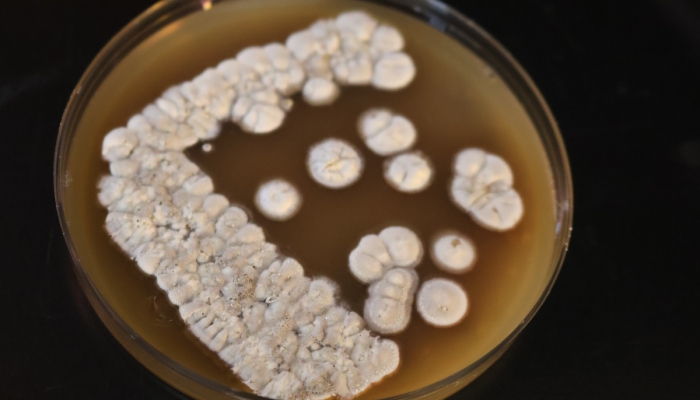

La IBEROestrena la carrera de Ingeniería en Biotecnología, un programa académico integral que articula la investigación, el desarrollo y la innovación para preparar al estudiantado a través de clases teóricas y situaciones de aprendizaje experimental en laboratorios y plantas piloto de bioprocesos para incidir en el desarrollo industrial de la farmacéutica, la cosmética, la agroalimentaria y otras más.

La plantilla académica está conformada por profesoras y profesores investigadores expertos en el área de conocimiento, entre ellos el Dr. Alejandro Torres Haro, Coordinador del programa, así como destacados académicos como la Dra. Ana Lilia Juárez-Vázquez, el Dr.Orlando de la Rosa y el Dr. Julio César López Velázquez.
![]() |
| De izquierda a derecha, la Dra. Ana Lilia Juárez-Vázquez, el Dr. Alejandro Torres Haro, Coordinador del programa, el Dr. Julio César López Velázquez y el Dr. Orlando de la Rosa. |
El perfil de egreso prepara a las y los estudiantes para investigar retos y oportunidades, evaluar y ejecutar soluciones sostenibles, e implementar y desarrollar bioprocesos innovadores, a través de la selección de herramientas biotecnológicas que respondan a los retos actuales de la sociedad.

Al concluir la carrera, podrán integrarse a laboratoriospúblicos o privados, industrias productivas, instancias gubernamentales o desarrollar emprendimientos biotecnológicos para generar bienes y servicios para la sociedad y el medio ambiente.
Quienes inician clases este 12 de enero se adentrarán en un área estratégica del conocimientoorientada a mejorar la calidad de vida, mediante metodologías de producción y recuperación de productos derivados de sistemas biológicos como plantas, animales y microrganismos, ya sean nativos o modificados genéticamente.
¿Qué aprenderá el nuevo estudiantado de Ingeniería en Biotecnología?
El plan incluye asignaturas como física, química, matemáticas (nivel básico y aplicado), así como materias directamente relacionadas con el área del conocimiento como la microbiología (básica y aplicada a escala industrial), bioquímica, ingeniería de fermentaciones, diseño y prototipado de biorreactores, bioseparaciones, biología molecular, ingeniería genética, biorremediación, aprovechamiento de residuos agroindustriales y, finalmente, aterrizar en el diseño de bioprocesos sustentables.

El estudiantado aprenderá a valorizar residuos orgánicospara diseñar medios de cultivo capaces de ser aprovechables por maquinarias metabólicas a escalas industriales para generar compuestos bioactivos —sustancias presentes en los alimentos con beneficios para la salud— que contribuyen a la prevención de enfermedades cardiovasculares, cáncer o diabetes y, subsecuentemente, promueven un envejecimiento saludable.

La IBERO ya trabaja con microorganismos capaces de producir antibióticos, proteínas/enzimas, biocombustibles, aditivos alimentarios, suplementos funcionales, cosméticos, biopolímeros, así como bioestimulantes que reducen el uso de agroquímicos que contaminan e medio ambiente.
Fiel a su visión humanista de formar no a los mejores del mundo, sino a los mejores para el mundo, nuestra casa de estudios ofrece infraestructura para generar conocimiento científico y tecnológico que permite la vinculación con empresas, universidades y centros de investigación.

¿Por qué estudiar Ingeniería en Biotecnología en la IBERO?
Porque la carrera también cuenta con una asignatura de Biotecnología Textil. También, fomentará el uso de herramientas digitales e Inteligencia Artificial (IA) y explorará alternativas no convencionales para transformar cadenas productivas e impulsar un enfoque de sustentabilidad.

Investigadoras e investigadores de la IBERO coinciden: un país sin biotecnología es un país limitado, incapaz de enfrentar desafíos como el cambio climático, el uso de energías, la contaminación y la escasez de recursos tanto farmacéuticos como alimentarios. Las y los futuros profesionistas del área serán capaces de evadir asumir retos para generar oportunidades.
¡Bienvenida la primera generación de Ingeniería en Biotecnologíade la IBERO! Nuevas y nuevos estudiantes que se adentran a la ciencia y a la tecnología, que impulsan soluciones creativas e innovadoras para México y para el mundo.
Notas relacionadas:

